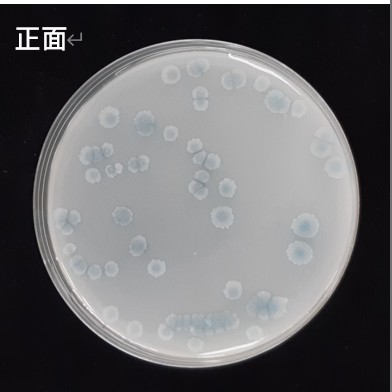

福壽 好菌旺1號|貝萊斯芽孢桿菌微生物肥料,提升磷肥利用率
福壽 好菌旺1號 (Bacillus velezensis,貝萊斯芽孢桿菌) 是一款專業研製的微生物肥料,含有本土優良溶磷菌株,具備磷酸三鈣的溶磷活性。長期施用能有效增加磷肥的有效性,提升肥料養分利用率,幫助作物在不同生長階段獲得更佳的養分支持。
產品特色
• 溶磷活性:促進土壤中磷肥轉化為可吸收型態,提升肥效。
• 養分利用率高:幫助作物更有效吸收氮、磷、鉀等養分。
• 適用廣泛:水稻、果樹、花卉、蔬果、苗木及茶樹皆可使用。
• 天然安全:本產品為天然活菌製成,適合環保栽培。
• 台灣製造:品質穩定,符合在地農業需求。
使用方法
• 水稻:插秧後14天內及曬田後淹田時使用。澆灌200~400倍,葉面噴施400~600倍。
• 落葉及常綠果樹:基肥、幼果期、中果期及落葉前追肥。澆灌200~400倍,葉面噴施300~500倍。
• 花卉、蔬果、苗木:幼苗期及生長中期。澆灌300~500倍,葉面噴施400~800倍。
• 茶樹:萌芽初至中期及採收前。澆灌200~400倍,葉面噴施300~500倍。
產品規格
• 容量:1號配方
• 有效年限:2年
• 製造地:台灣
⚠️ 注意事項
1. 請存放於陰涼乾燥處,避免陽光直射,並防止人畜誤食。
2. 可與栽培介質或其他肥料混拌使用,搭配有機質肥料效果更佳。
3. 本產品為天然活菌,使用時勿與銅劑或抗生素類殺菌劑混合;灌溉土壤前後7日內避免使用殺菌劑。
福壽 好菌旺1號結合貝萊斯芽孢桿菌的溶磷活性,能有效提升磷肥利用率,促進作物養分吸收,是水稻、果樹、花卉、蔬果及茶樹栽培的理想選擇。選擇好菌旺1號,讓您的作物更健康、更高產,栽培更安心。
物流說明


配送方式

- 小7:9公斤,全家:6公斤
- 包裝限制:45*30*30cm
- 便利商店僅服務註冊會員
- 配送約3~4日

- 可寄送總重量大於20公斤
- 無寄送偏遠山區及離島地區
- 偏遠地區定義:沒在你家附近出現過
- 配送約1~3日(不含例假)

- 單件重量不超過20公斤
- 包裹總長不可超過150公分
- 無寄送離島地區
- 配送約1~3日(不含例假)

- 單件重量不超過19.5公斤
- 包裹總長不可超過150公分
- 無寄送離島地區
- 可指定配送時間
- 配送約1~3日(不含例假)

- 單件重量不超過19.5公斤
- 包裹總長不可超過150公分
- 可寄送偏遠山區及離島地區
- 配送約1~3日(不含例假)

- 港、澳會員(專用物流)
- 匯款後貨到付運費
- 送時間約為7日內(不含例假)
付款與配送
| 轉帳匯款物流直送 | 貨到付款 | 網路信用卡刷卡 | |
 |
|||
 |
|||
 |
|||
 |

必看
調皮、淘氣的客人
- 吃飽飯來逛街的
- 自取"必看"沒看的
- 打破砂鍋問到底的
- 愛亂殺價的
- 臨時自取,門口狂按電鈴的
- 拿出鐵青的千元大鈔要找零的
- 隱瞞身分來探路的
- 2026目前頑皮人數:1
有閱讀自取的好康
- 幾乎不收尾數零頭
- 亂送消費者用的到產品
- 如倉庫有即期品任君免費挑一種
- 以上好康前題是前天沒跟老婆吵架
相關商品